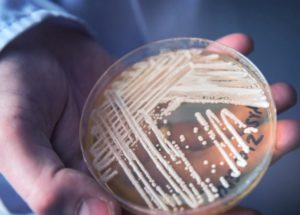
Deadly Drug-Resistant Pathogen Emerged In Canada

Antibiotics Might Help Alleviate Alzheimer’s Disease Symptoms
New researchers are showing that an antibiotic mix has impacted the bacteria from the mice’s gut, and they have reached to a point where the growth and development of Alzheimer’s disease have been slowed in males. The University of Chicago,…